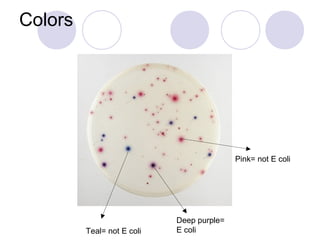
Colors




                                           Pink= not E coli




                            Deep purple=
         Teal= not E coli   E coli

Embed presentation
Download to read offline








Coliquant EZ Gel is a petri dish test used to detect E. coli and coliform bacteria in water samples. Water samples are collected in clean, cold bottles and poured onto a growth medium in the petri dish back at the lab. The medium feeds the bacteria, allowing them to multiply and form visible colonies during incubation. The number and color of colonies indicate the presence and levels of coliform and E. coli bacteria, with deep purple colonies specifically identifying E. coli.